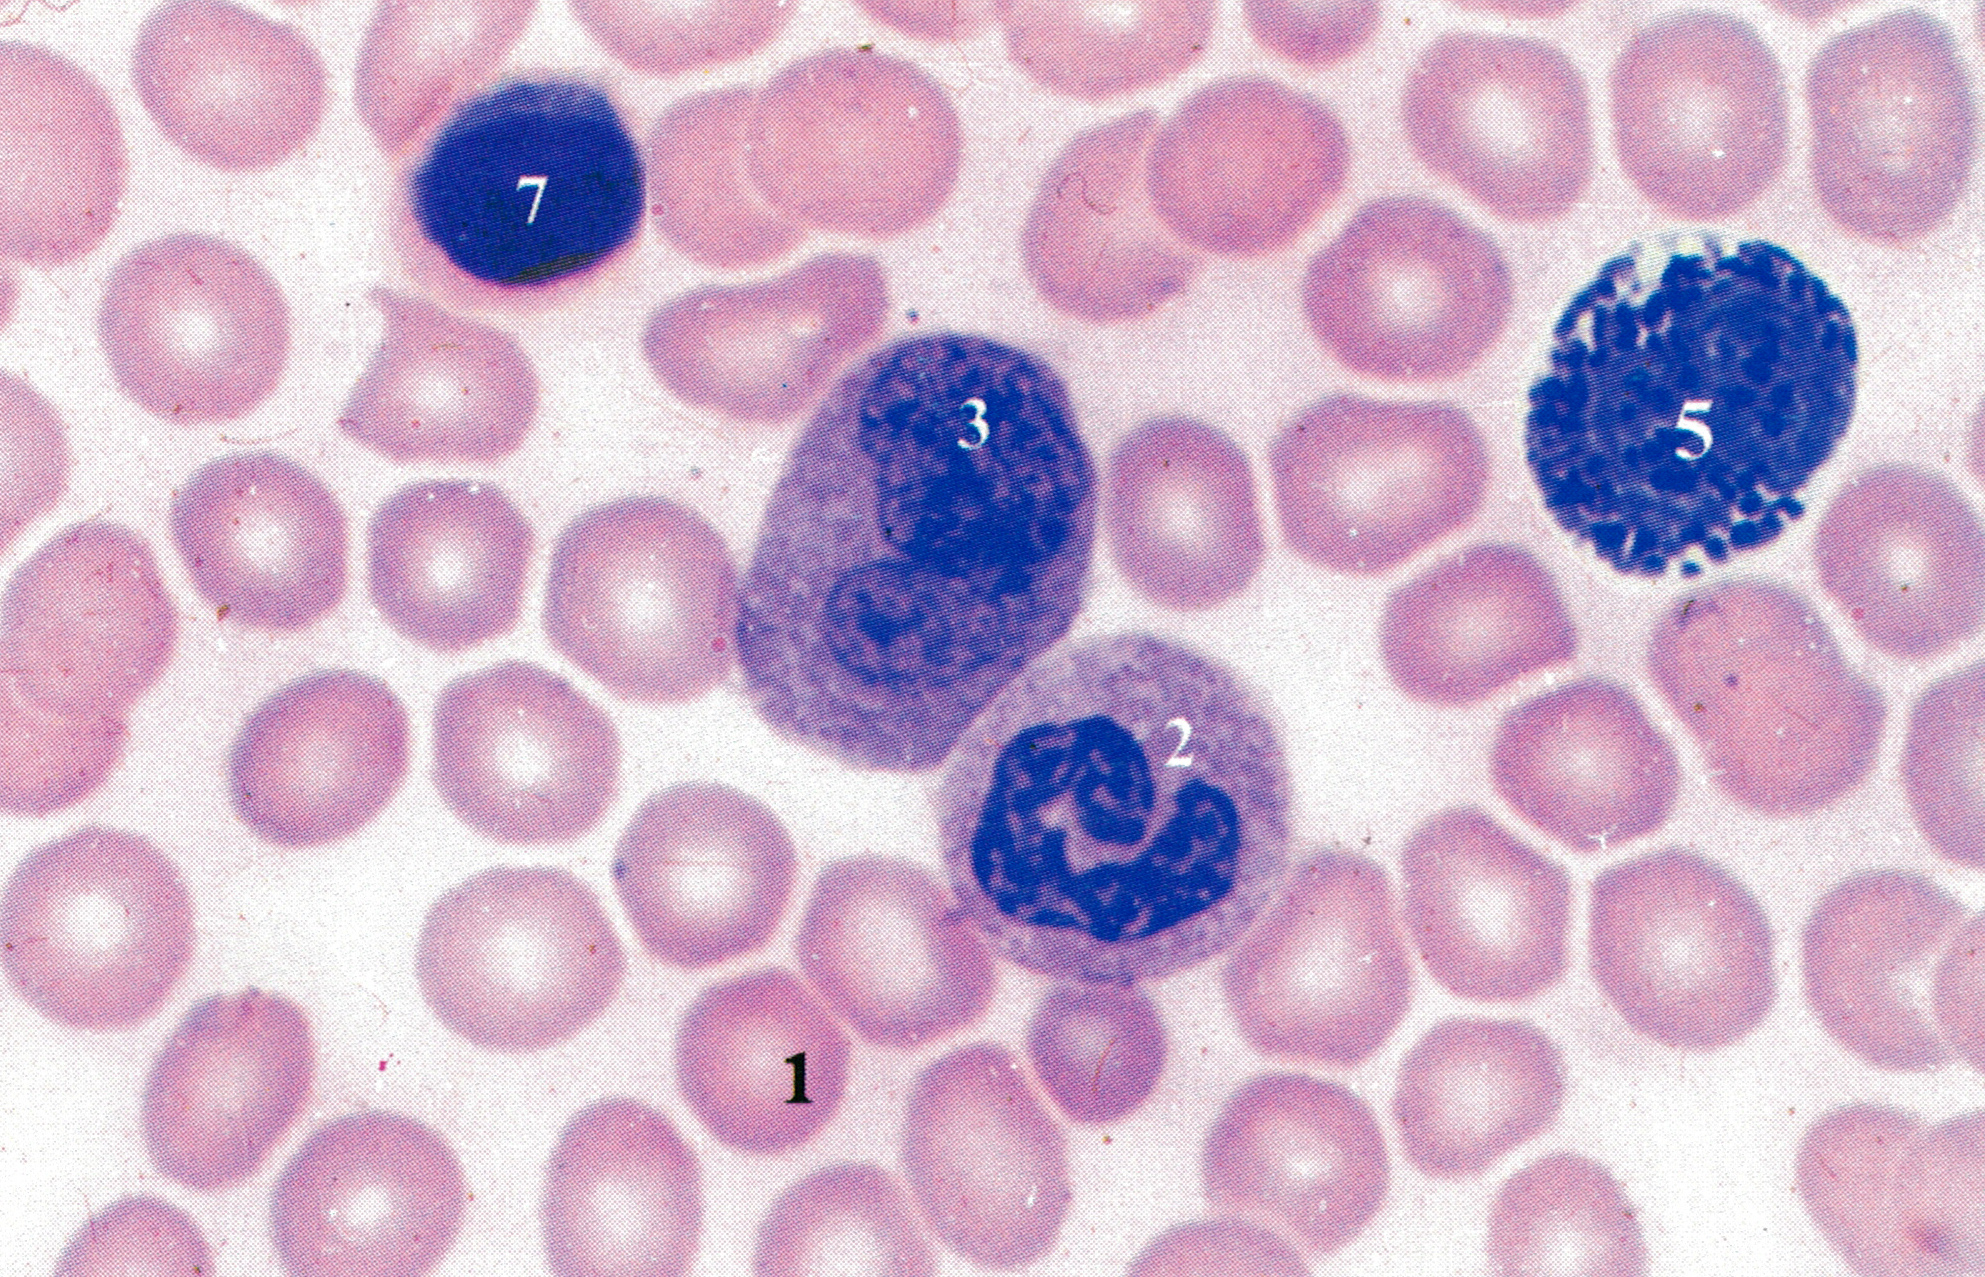
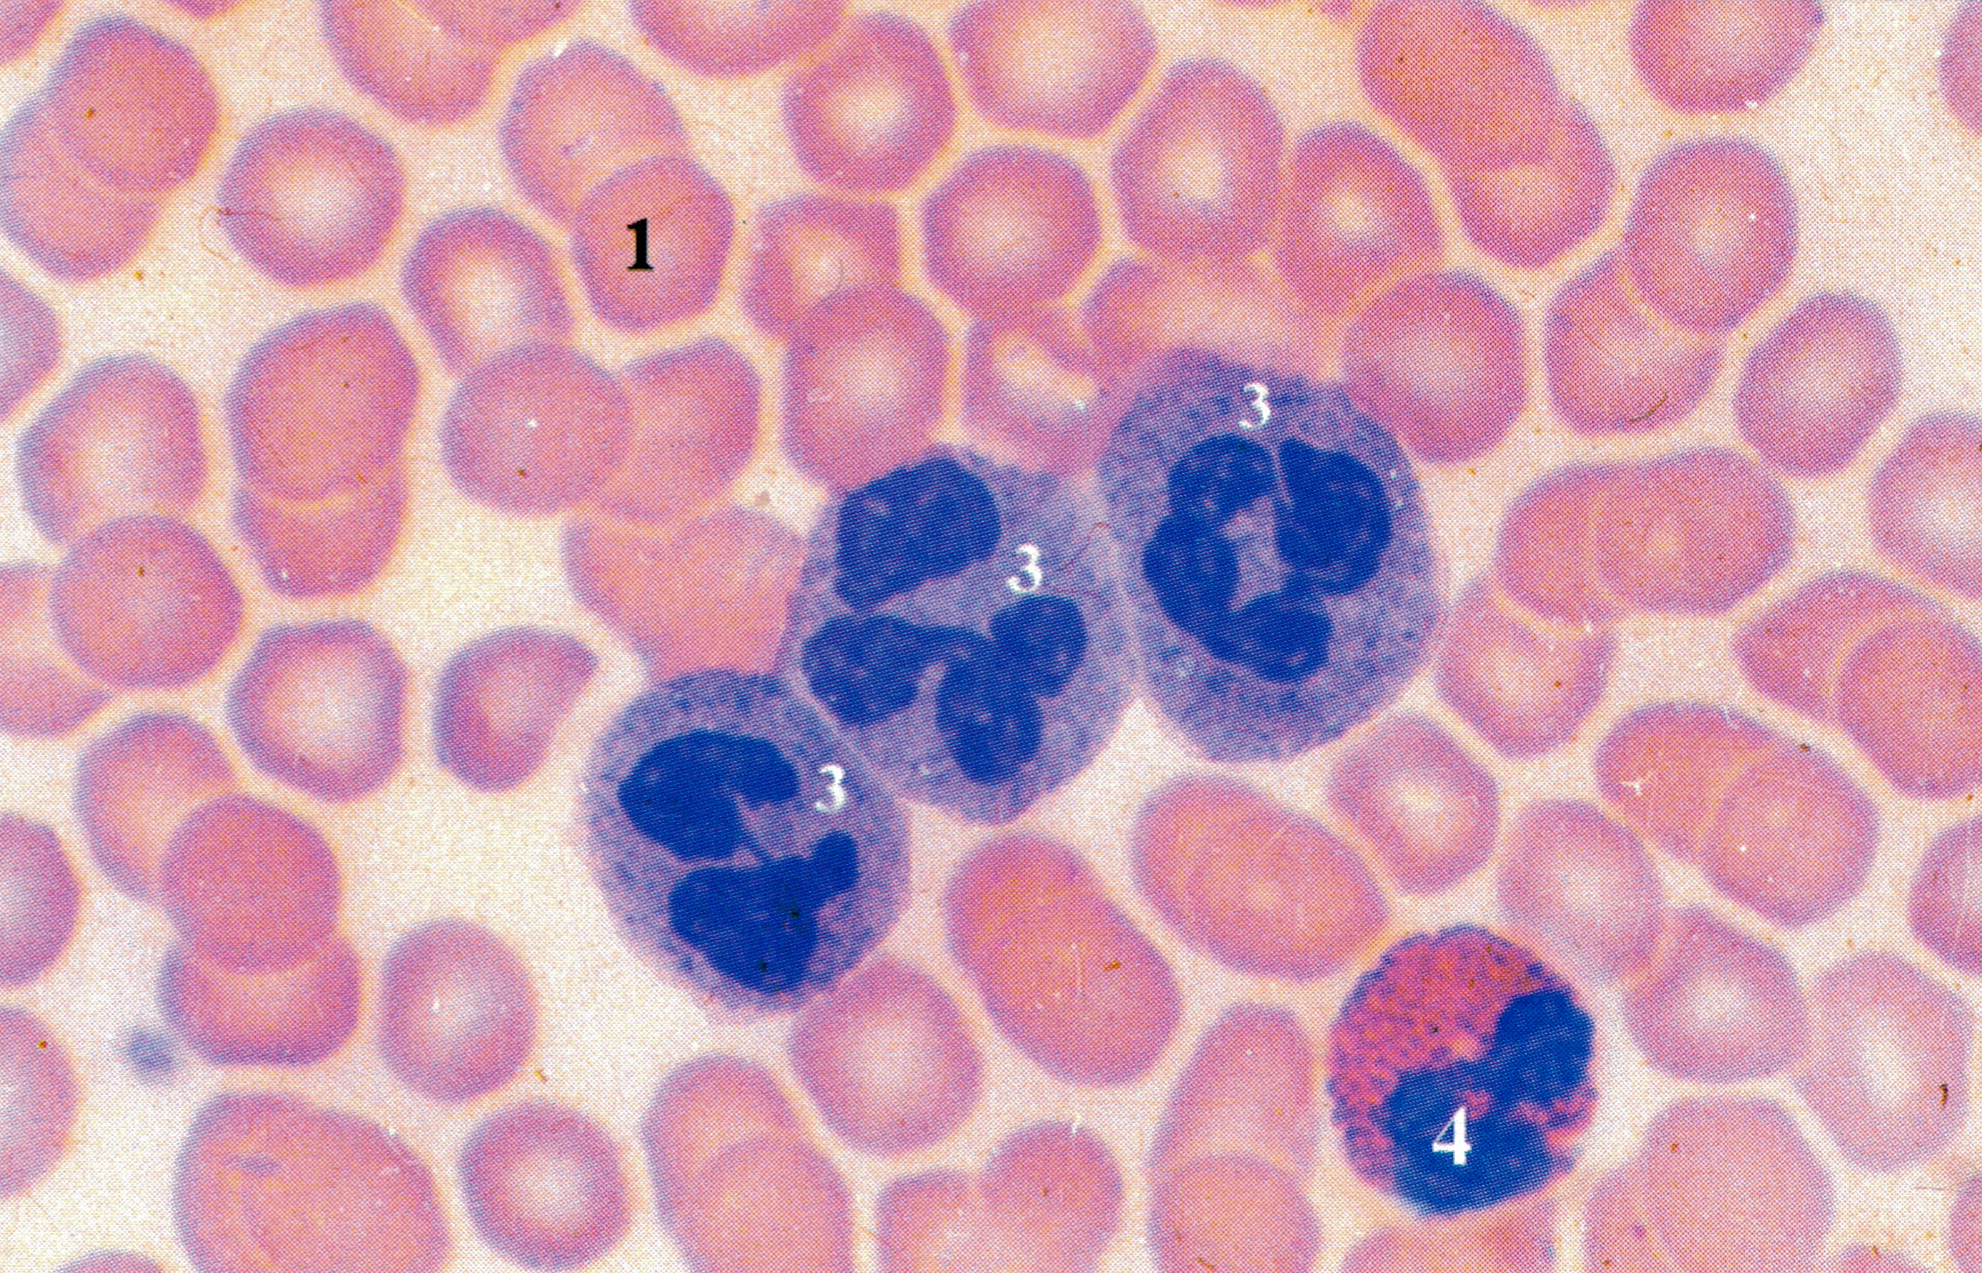
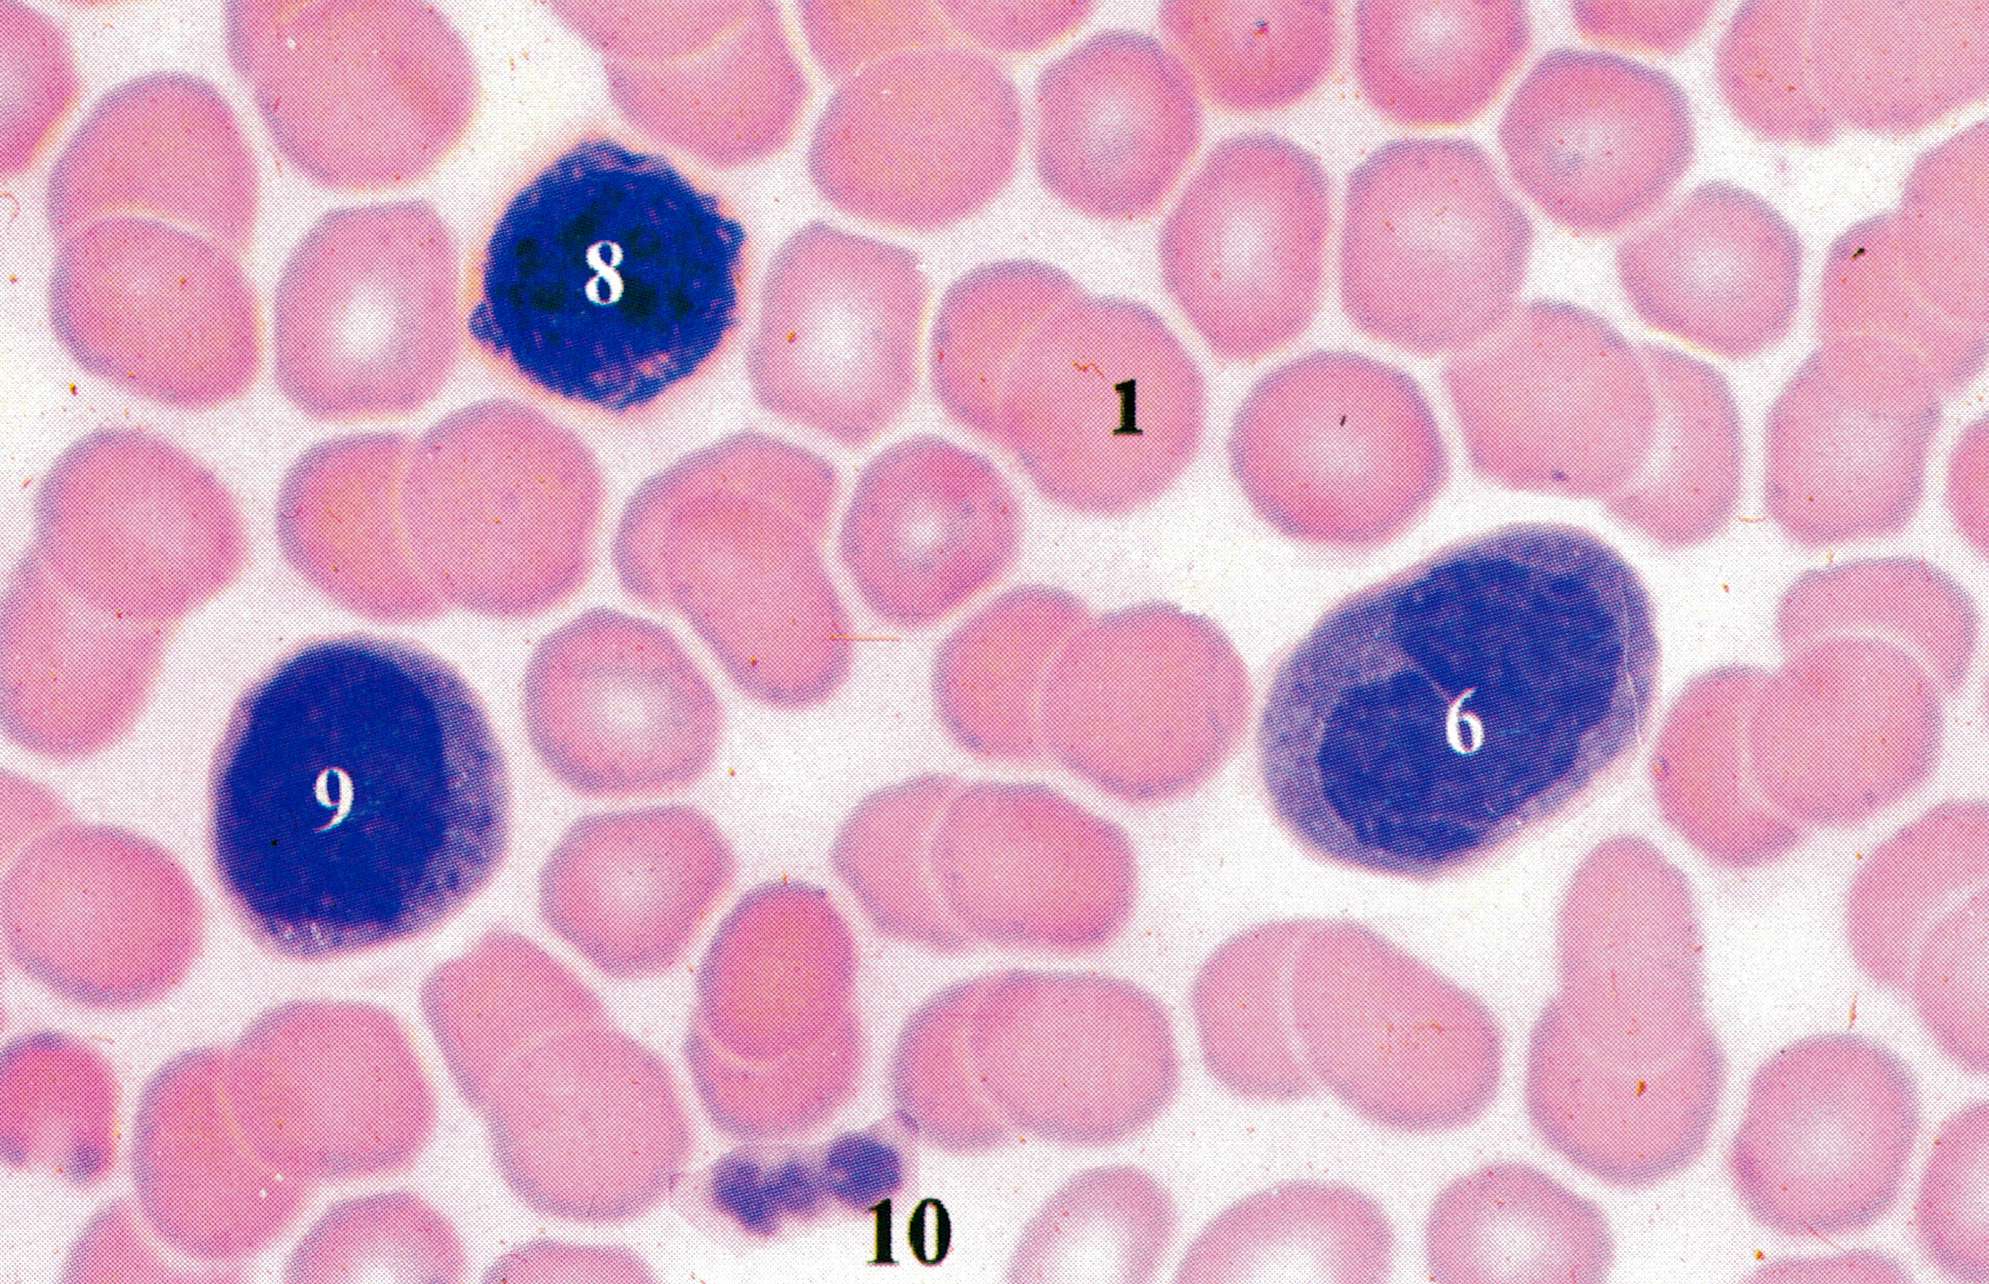

1、上皮组织的观察
(1)单层扁平上皮

单层扁平上皮(表面观)蟾蜍肠系膜铺片镀银染色3.3 x40(上海医大)
上皮细胞呈多边形,相互嵌连,排列紧密。细胞间物质(粘合质,
cement)着色深,呈黑色锯齿状。细胞核圆形,淡染。
表面观:细胞呈多边形,胞核扁圆形,位于细胞中央
垂直观:细胞扁平,中央有核处较厚,其余部分胞质很薄
分布:
1)衬贴于心脏、血管和淋巴管腔面:内皮(endothelium)

人小动脉内膜内皮 HE染色3.3×40 (上海铁医,上海医大)
2)分布于胸膜、腹膜、心包膜内表面:间皮(mesothelium)

人阑尾浆膜间皮 HE染色3.3×40 (上海铁医,上海医大)
3)分布于肺泡和肾小囊壁层等

人肾脏肾小囊壁层上皮 HE染色3.3×40 (上海铁医,上海医大)
(2)单层立方上皮
表面观:细胞呈六角形
垂直观:细胞立方形,核圆居于细胞中央

单层立方上皮HE染色3.3×40(上海医大)
图示狗甲状腺滤泡上皮(↑),单层立方上皮( simple cuboidal epithelium)由一层立方形细胞组成,核圆形,位居中央(↑)。具有分泌功能的xi上皮(glandular epithelium)多由单层立方或单层锥体形细胞组成,如汗腺和唾液腺的分泌部等。
分布:肾小管、小叶间胆管、甲状腺滤泡上皮等
(3)单层柱状上皮
表面观:细胞呈
垂直观:细胞呈柱状,核长圆形,靠近基底部

单层柱状上皮人小肠 HE染色3.3×40 (上海医大)
小肠粘膜表面的上皮内还可见杯状细胞( goblet cell)(↓)。上皮细胞呈高柱状,核长圆形,位近细胞基部。小肠上皮游离面呈深红色的线状结构为纹状缘( striated border)(△)。
分布:胃、肠、子宫等
(4)假复层纤毛柱状上皮
由柱状细胞、梭形细胞、锥体形细胞和杯状细胞构成

假复层纤毛柱状上皮人气管HE染色 3.3 x40(上海医大)
气管粘膜上皮内纤毛细胞较多,纤毛多而长(↓),向口腔方向摆动,有助分泌物和尘粒等的排出,净化呼吸道。上皮内有杯状细胞(▲)(参见图01 - 005C)。上皮基部的基膜(basement membrane)明显,呈粉红色均质状(△)。
分布:呼吸道
(5)复层扁平上皮
由基底面向游离面依次是:
基底细胞 →多边形细胞 →扁平细胞
角质化 非角质化
皮肤的表皮 口腔、食管、阴道
①非角质化

复层扁平上皮HE染色3.3x40(上海医大)
人食管腔面示未角化的复层扁平上皮( nonkeratinized stratified squamous epithelium)o上皮厚,由数十层细胞组成。深层细胞立方形,中间层细胞多角形,浅层细胞渐变为扁平状,表层细胞更扁而薄(↓)。

复层扁平上皮HE染色3.3x40(上海铁医)
人手指表皮示角化的复层扁平上皮( keratinized stratified squamous epithelium)。上皮尤厚,浅层细胞完全角化,细胞干硬死亡,胞质内充满角蛋白,核消失不见。浅部的角质层呈均质状,表层细胞不断脱落(↑)。
复层扁平上皮基底面与深部结缔组织之间的连接凹凸不平,结缔组织凸向上皮形成乳头(▲)。此类上皮耐磨擦,具很强的机械性保护作用,尤以角化型上皮为甚。最深层的基底层细胞分裂分化能力强,不断增殖分化,补充表层细胞的脱落。
(6)变移上皮
特点:上皮的层次和细胞形态随所在器官的收缩或舒张而改变
由基底面向游离面依次是:基底细胞 → 中间层细胞 →表面细胞
分布:肾盂、肾盏、输尿管、膀胱

变移上皮人膀胱HE染色3.3x40(上海医大)
变移上皮( transitional epithelium)为复层(或认为是假复层)上皮,覆于肾盏\肾盂\输尿管\膀胱的腔面。表层细胞较大,呈立方形或多角形,称盖细胞( tectorial cell)(↓),表面胞质较致密,形成深染的壳层,有的细胞具双核。此类上皮的特点是上皮细胞层次和形状可随器官的扩张(尿液充盈)和收缩(排尿后)而变化。
2、结缔组织
(1)疏松结缔组织
低倍镜下疏松结缔组织内有许多染色浅红、结构疏松、长短不同的胶原纤维切面(各种不同方 向的切面);纤维之间可见一些紫蓝色的细胞核,为结缔组织细胞的核。高倍镜 下,可见胶原纤维的各种切面(纵、横、斜切面);还可见许多折光性强的弹性纤维;胶原纤维之间见到的细胞核,多是成纤维细胞的细胞核,椭圆形或梭形,染色浅,有时可见核仁,细胞境界不清,胞质染色浅。其他细胞常分辨不清。疏 松结缔组织中含有许多小血管,腔小、壁厚、形状规整的是小动脉;腔大、壁薄、 形状不规则的是小静脉。

疏松结缔组织铺片兔皮下组织兔活体注射台盼蓝+醛复红染色+偶氮洋红染色5 x20.(上海医大)
在玻片上拉摊而成的皮下组织薄片,纤维稀疏交错,细胞散在分布。呈粉红色粗细不一的条带为胶原纤维( collagen fiber).呈紫蓝色均一的细丝为弹性纤维( elastic fiber)。细胞核均着红色。成纤维细胞( fibroblast)数量多,但胞质染色很浅,细胞轮廓不清,仅见椭圆形的细胞核(↑)。巨噬细胞( macrophage)胞质内含大量吞入的台盼蓝颗粒,标志明显,轮廓清晰(△)。成纤维细胞增殖能力强,有生成纤维和基质的作用。功能静止状态的成纤维细胞称纤维细胞( fibrocyte)。
(2)致密结缔组织
主要构成肌腱和腱膜。大量密集的胶原纤维顺着受力的方向平行排列成束,基质和细胞很少,位于纤维之间。细胞成分主要是腱细胞,它是一种形态特殊的成纤维细胞,胞体伸出多个薄翼状突起插入纤维束之间,胞核扁椭圆形,着色深。

规则的致密结缔组织人肌腱HE染色3.3×20(上海医大)
大量胶原纤维束密集平行排列,基质很少,细胞也较少。细胞位于纤维之间,呈扁平状,有突起,称腱细胞,是一种成纤维细胞。肌腱和腱膜的纤维顺受力方向平行排列,起牢固的连接作用。
(3)网状组织
网状组织分布在整个淋巴结中,构成支架。低倍镜下,选择髓质 中染色浅淡处观察,此处为髓质淋巴窦(髓窦),因窦腔中细胞成分较少,便于 观察网状组织。高倍镜下,可见网状细胞为多突起的细胞,胞质嗜酸性红染,相 邻的网状细胞的突起彼此相连成网。网状细胞的核大而明亮,核仁明显。网状细 胞围成的网眼中可见许多淋巴细胞。淋巴细胞圆形,核亦圆,着色深,胞质少, 不易看见。网状纤维细小,紧贴着网状细胞的突起行走.

网状纤维猫淋巴结镀银染色5x20 (上海医大)
网状纤维( reticular fiber)具嗜银性,又称嗜银纤维(argyrophil fiber),淋巴器官和造血器官内有较多的网状纤维。图示淋巴结髓质,黑褐色的网状纤维呈分支细网状。网架之间有许多散在的细胞,核均深染呈黑色,胞质淡而不明显,其中核较大、胞质较多的为网状细胞( reticular cell);核小而圆的为淋巴细胞。网状细胞和网状纤维组成网状组织( reticular tissue),是构成淋巴器官和造血器官等的支架成分。
(4)脂肪组织
脂肪组织由大量单泡脂肪细胞集聚而成,细胞中央有一大脂滴,胞质呈薄层,位于细胞周缘,包绕脂滴。在HE切片上,脂滴被溶解成一大空泡。胞核扁圆形,被脂滴推挤到细胞一侧,连同部分胞质呈新月形。黄色脂肪组织主要分布在皮下、网膜和系膜等处,约占成人体重的10%,是体内最大的贮能库,参与能量代谢,并具有产生热量、维持体温、缓冲保护和支持填充等作用。

脂肪组织人皮下组织HE染色3.3×20(上海医大)
通常所称的脂肪组织( adipose tissue)为黄(白)色脂肪组织,主要由单泡脂肪细胞聚集而成,分布广泛,其分布状况和量的个体差异甚大。脂肪组织是机体的贮能库,并有保持体温和缓冲\支持等作用。

脂肪细胞3.3x40 (上海医大)
人皮下组织HE染色脂肪细胞(adipocyte,fat cell)胞质内含一大脂滴,在常规制片过程中脂质被溶解而呈空泡状。脂滴外周为薄层胞质,核也被脂滴推挤至细胞一侧,呈扁平状(↑)。通常所称的脂肪细胞即此种单泡脂肪细胞,细胞分布广泛,多聚成群,构成脂肪组织。
(5)软骨组织
①透明软骨

透明软骨人气管HE染色3.3×20(上海医大)
透明软骨( hyaline cartilage)是分布较广泛的一种软骨。图一侧为软骨膜( perichondrium)(△),软骨膜与软骨组织之间呈逐渐演变的过程。近软骨膜处的软骨细胞( chondrocyte)较小,扁平状,散在分布;深部的软骨细胞较大,细胞分裂增生形成同源群( isogenousgroup)分布。在制片过程中,软骨细胞多因脱水而皱缩,致使陷窝明显可见(↓)。软骨基质呈紫蓝色均质状,陷窝外周的基质嗜碱性,着色更深,为软骨囊(cartilage capsule)o透明软骨的结构特点与其两种生长方式相关。透明软骨间质内的胶原原纤维无横纹,不形成粗大的胶原纤维,折光性与基质相近,故呈透明状。
②弹性软骨

弹性软骨入耳壳弹性纤维染色3.3×20(上海铁医)
一侧为软骨膜。弹性软骨( elastic cartilage)间质内含大量弹性纤维,呈蓝黑色,交织成网,软骨囊处尤为密集。软骨边缘处的弹性纤维与软骨膜的弹性纤维相连续。软骨细胞体积较大(核着红色),同源群现象不及透明软骨明显。
③纤维软骨

纤维软骨人椎间盘HE染色2.5×20(上诲铁医)
纤维软骨( fibrous cartilage)的间质多,细胞少。间质内含大量胶原纤维,纤维与基质的分布不均,故间质呈不均匀的红色和紫蓝色。细胞较小,也可见陷窝。细胞大多散在分布,可见少量同源群现象。
(6)骨组织

骨密质(横切)兔长骨脱钙切片硫堇染色3.3x2(上海医大)
长骨干横切面。骨密质( compact bone)外内两面分别为外环骨板(outer circumferential lamella)和内环骨板(inner circumferential lamella),前者较平整,后者不平整,与骨小梁相连,厚薄不一(△)o中间较厚的部分由许多骨单位(osteon,Haversian system)和间骨板构成。骨单位呈圆柱形,沿骨长轴平行排列,穿越其中轴的管道为中央管( central canal,Haversian canal)(↑为横切面)。横向穿越外环骨板或内环骨板以及连接中央管之间的管道称穿通管( perforating canal,Volkmann canal)(▲)。

骨密质(横切)兔长骨脱钙切片硫堇染色)3.3×10(上海医大)
骨单位的横断面呈圆形,中央管(↓)内含的血管、淋巴管、神经及骨膜组织等已难辨认。多层环形骨板沿中央管呈同心圆排列,呈黑色的骨陷窝也呈环形排列,在骨陷窝之间呈放射状的细管为骨小管。骨单位之间的不规则形的骨组织为间骨板( interstitial lamella)(★)。骨单位是长骨干起支持作用的主要结构单位。

骨密质(横切)兔长骨脱钙切片硫堇染色3.3×40(上海医大)
骨单位横切面高倍,环行排列的骨陷窝( bone lacuna)及与其相通连的放射状的骨小管(bone canaliculus)更清晰可见。活组织的骨陷窝和骨小管内分别含有骨细胞( osteocyte)的胞体和突起以及流动的组织液。骨单位周边的环行淡染带为粘合线(cement line),相邻骨单位周边的骨小管不在粘合线处相通连。
(7)血液
血细胞约占血液容积的45%,包括红细胞、白细胞和血小板。在正常生理情况下,血细胞和血小板有一定的形态结构,并有相对稳定的数量。红细胞直径7~8.5μm,呈双凹圆盘状,中央较薄(1.0μm),周缘较厚(2.0μm),故在血涂片标本中呈中央染色较浅、周缘较深。在扫描电镜下,可清楚地显示红细胞这种形态特点。

血细胞人血液涂片瑞特染色(W-ight stain-ing)3.3×100(A、B、C)(上海铁医,上海医大)
图示红细胞(l),中性粒细胞(杆状核)(2),中性粒细胞(分叶核)(3),嗜酸性粒细胞(4),嗜碱性粒细胞(5),单核细胞(6),小、中、大淋巴细胞(7,8,9),血小板(10)o红细胞(erythrocyte)较小,双凹圆盘形,中央薄,染色浅,周边厚,染色深,胞质内充满血红蛋白( hemoglobin),无核,无细胞器。红细胞具有结合和运输02与CO2的功能。中性粒细胞(neutrophil)的核呈杆状或分叶(25叶),胞质内可见淡红色的细小颗粒;细胞具有趋化性运动和吞噬能力,急性炎症时增多,在病灶处吞噬细菌等,变为脓细胞( pyocyte)。嗜酸性粒细胞( eosinophil)的核多分2叶,胞质内含染深红色的粗大颗粒,在感染寄生虫和变态反应时增多;细胞具趋化性运动,能吞噬抗原抗体复合物,释放组胺酶( histaminase),减轻过敏反应。嗜碱性粒细胞( basophil)的核形不规则或分叶,胞质内含染紫蓝色大小不一的颗粒;细胞性能与肥大细胞相似,可释放组胺\白三烯和肝素。单核细胞( monocyte)体积较大,核呈肾形,染色质松散呈细网状,胞质着灰蓝色,内含细小的嗜天青颗粒( azurophilic granule);细胞具趋化性运动和吞噬能力,穿出血管外分化为巨噬细胞,总称单核吞噬细胞系统( mononuclear phagocytic system)o淋巴细胞( lymphocyte)的核圆形或椭圆形,染色质较浓密而着色深,胞质呈蔚蓝色,含少量嗜天青颗粒;细胞体积大、中、小不一,小淋巴细胞居多,它们均具有重要的免疫功能,按功能性质分为T细J咆( thymus - dependent lymphocyte,T cell)\细胞(bone mar-row - dependent lymphocyte,B cell)\杀伤(K)细胞(killer cell)和自然杀伤(NK)细胞(natural killer cell)o血小板(blood platelet)是骨髓巨核细胞( megakaryocyte)胞质脱落的小块,体积甚小,无核,胞质内有线粒体、微丝、微管等细胞器,还可见血小板颗粒;血小板在凝血和止血过程中起重要作用。
3、肌肉组织
(1)骨骼肌
低倍镜下,可见表面上皮为复层扁平上皮,上皮下方有疏松结缔 组织,深部组织中有许多条条块块结构,条状的为骨骼肌的纵断面,块状的为骨骼肌的横断面;每一条状或块状结构包含多条骨骼肌纤维的断面。肌纤维之间有少量结缔组织,其内可见浆液性的味腺。选择肌纤维较分散、染色较浅的视野,换高倍镜观察。在纵断面上,可见骨骼肌呈条索状,有明暗相间的横纹(观察横纹时,缩小光圈,使通光量减小,横纹将更为清晰);每条肌纤维内均有许多紧贴肌膜内面的长卵圆形胞核,染色浅,有时可见核仁;肌浆中隐约可见许多平行于肌纤维长轴排列丝状结构,即肌原纤维。在横断面上,肌纤维呈圆形或不规则形,每个断面常可见数量不定的胞核位于肌纤维的周边,肌浆内肌原纤维束呈点状均匀分布。肌纤维间的结缔组织中可见小血管。

骨骼肌人舌体HE染色 3.3×10(A) 3.3×40(B,C)(上海铁医)
骨骼肌纤维( skeletal muscle fiber)纵切,纤维细而长,平行排列成束,纤维间有结缔组织和血管。

骨骼肌人舌体HE染色 3.3×40(上海铁医)
骨骼肌纤维纵切,纤维形似长带状,核卵圆形,数量多,位于肌膜下(↑)。由肌丝组成的肌原纤维(myofibril)沿肌纤维长轴平行排列,具规律的明暗相间的横纹。

骨骼肌人舌体HE染色 3.3×40(上海铁医)
骨骼肌纤维横切面,呈不同形状的块状,核位于边缘。胞质内的肌原纤维(横切)被肌浆( sar-coplasm)分隔成小束,称孔海姆区(Cohnheim field)。


(2)心肌
低倍镜下,心肌纤维走向无一定规则,空白或淡染处为心肌纤维束间隙,每束心肌纤维又含许多条肌纤维。选择心肌纤维的纵断面,高倍镜下可见心肌细胞互相平行排列,但有分叉,彼此吻合成网,细胞境界不如骨骼肌纤维清楚;心肌纤维的直径比骨骼肌纤维小,有横纹,但不如骨骼肌纤维明显;细胞核单个,卵圆形,染色浅,位于中央;胞质丰富,显色较淡,特别是核周围胞质更浅淡,此处有时还可见脂褐素颗粒;心肌纤维端端连接处,常可以见到深染的带状结构,如同一较粗的横纹,此即为闰盘,闰盘是心肌纤维的特有结构。心肌纤维的横断面,呈圆形或不规则形的小块,有的有圆形染色浅淡的细胞核,有的无核,横断面的中央常染色较浅。

心肌人心脏HE染色3.3×40(上海二医大)
心肌纤维( cardiac muscle fiber)纵切,纤维呈柱状并分支框互连接,有明暗相间的横纹。核椭圆形,位居中央,有的肌纤维含双核,核周胞浆较多,着色较浅,可见内含的呈黄褐色的脂褐素(△)。闰盘( intercalated disc)呈深染的直行或阶梯状横线(↑),是由肌纤维间的连接结构所形成。

心肌人心脏HE染色3.3×40(上海医大)
心肌纤维横切,纤维呈圆形,较骨骼肌纤维小。核居中心,未切到核的肌纤维中央富含肌浆而着色浅,肌原纤维(或称肌丝束)的横切呈细点状,分布在肌纤维的周边部。肌纤维间细胞的核染色较深,主要是成纤维细胞。
(3)平滑肌
纤维呈长梭形,无横纹。细胞核一个,呈长椭圆形或杆状,位于中央,收缩时核可扭曲呈螺旋形,核两端的肌浆较丰富。平滑肌纤维大小不一,一般长200μm,直径8μm;小血管壁平滑肌短至20μm,而妊娠子宫平滑肌可长达500μm。平滑肌纤维可单独存在,绝大部分是成束或成层分布的。

平滑肌人小肠HE染色3.3×40(上海医大)
平滑肌纤维( smooth muscle fiber)纵切,肌纤维呈梭形,平行排列,相互错开。无横纹。核单个,椭圆形或呈长杆状,位于中央。肌纤维间的细丝(有的横过肌纤维)是缠绕在其表面的结缔组织纤维(网状纤维)。

平滑肌人小肠HE染色3.3×40(上海医大)
平滑肌纤维横切,肌纤维呈大小不一的小块状。经肌纤维中部的切面可见位居中央的细胞核,经纤维两端处的切面无核。
4、神经组织
(1)多极神经元

多极神经元(肠肌神经丛)猫小肠肠肌神经丛铺片镀铅染色2.5×20(上海医大)
小肠肠肌神经丛 ( myenteric nerve plexus,Auerbach nerve plexus)由多极的内脏运动神经元和神经纤维组成。神经元胞体及其突起呈棕黑色,胞体内的核着色略淡,胞质内神经原纤维呈细丝状。细胞突起多,细而长,交织成网。

多极神经元的尼氏体猫脊髓HE染色5x40(上海铁医)
示一个前角神经元,有多个突起( neurite),胞体(soma)内的核大而圆,染色浅,核仁明显。核周质( perikaryon)内的尼氏体较大而多,切片中所见形似”虎斑”。一个突起内无尼氏体,为轴突(axon)(↑),其起始部胞质内无尼氏体而色浅,为轴丘(axonhillock)。其余突起内含多少不一的尼氏体,为树突(dendrite)o尼氏体是由群集的粗面内质网和核糖体组成,轴突内无尼氏体,不能合成蛋白质。

多极神经元的神经原纤维猫脊髓镀银染色5 x40(上海医大)
神经元胞体和突起染成棕褐色。图示前角内多突起的神经元,核大而圆,淡染。胞质内的神经原纤维( neurofibril)呈棕黑色细丝,从胞体延伸入树突和轴突内。神经原纤维是由细胞骨架(中间丝和微管)构成,与胞体和突起内物质运输有关。神经元胞体四周交织的索状结构为其他神经元突起。
(2)神经胶质细胞
①星形胶质细胞

星形胶质细胞人大脑皮质镀银染色2.5×10(A)(上海医大)
显示大脑皮质内大量星形胶质细胞( astrocyte)(↑),黑褐色的细胞多突起,呈星形,其中多数为纤维性星形胶质细胞。黑色条索为血管(△)。星形胶质细胞构成大脑皮质和髓质的支架,并参与组成血脑屏障,还与神经元的物质代谢相关。
②少突胶质细胞

少突胶质细胞兔大脑皮质镀银染色3.3×40(上海医大)
少突胶质细胞( oligodendrocyte)染成黑色。胞体近圆形,突起少而短,分支也少(↑)。少突胶质细胞的突起包卷神经元轴突并形成髓鞘,故它是中枢神经系统内的髓鞘形成细胞。
③小胶质细胞

小胶质细胞兔大脑皮质镀银染色3.3×20(上海铁医)
小胶质细胞( microglia)染成黑色。胞体多呈梭形,突起较细长,常从胞体的两极伸出,突起上有小刺样结构(↑)。小胶质细胞的来源和性质不同于其他胶质细胞,它源于血液单核细胞,有吞噬功能,属单核吞噬细胞系统。
(3)神经纤维
①有髓神经纤维

有髓神经纤维猫坐骨神经HE染色3.3×40(上海医大)
有髓神经纤维纵切。坐骨神经主要由有髓神经纤维( myeli-nated nerve fiber)组成,每条神经纤维由神经元轴突(axon)及其外包的施万细胞( Schwann cell)形成的髓鞘(myelin sheath)构成。郎氏结( Ranvier node)处的结构较清晰(↑),可见一条深染的轴突穿行于中央,轴突外面的髓鞘脂类物质被溶解而呈空白区,扁平的施万细胞核位居纤维的周边(△)。郎氏结是两个施万细胞相邻接处,此处无髓鞘而呈缩窄状。

有髓神经纤维猫坐骨神经HE染色3.3×40(上海医大)
有髓神经纤维横切。一侧为神经外膜(下),神缢纤维断面呈大小不一的圆形,中央深染的小点为轴突,外周淡染呈网格状的为髓鞘,有的可见位于纤维边缘的施万细胞核。
②无髓神经纤维

无髓神经纤维狗交感神经HE染色3.3×20(上海医大)
图示无髓神经纤维( unmyelinated nerve fiber)纵切,一侧为神经外膜,可见脂肪细胞(丁)。神经纤维较细,无髓鞘和郎氏结。纤维排列紧密,施万细胞和成纤维细胞的核均为扁平形,较难辨认区分。
(4)神经末梢
①游离神经末梢

游离神经末梢猪鼻部表皮镀银染色3.3×20(上海医大)
表皮呈棕黄色,一侧深染的山峰状结构为真皮结缔组织突向表皮的乳头,其内含呈棕黑色的神经纤维网。可见一支轴突末梢(已失去施万细胞)伸入表皮内,其末端在细胞间分为细支(↑)。此即游离神经末梢( free nerve ending),感受触、痛、冷、热等刺激。
②有被囊的神经末梢
触觉小体

触觉小体人指尖皮肤3.3×20(上海医大)
镀银染色表皮和真皮乳头清晰,乳头内可见染成黑色的神经纤维轴突(脊神经节假单极神经元的周围突)末梢在触觉小体内弯曲盘绕(↑)。触觉小体感受触摸刺激。

触觉小体人指尖皮肤3.3×20(上海医大)
HE染色表皮为角化的复层扁平上皮,下方浅染的为真皮结缔组织向表皮基部突入形成的乳头。触觉小体(tactile corpuscle,Meissner corpuscle)位于乳头内,椭圆形,外包结缔组织被囊(cap-sule),内部为横列的扁平细胞(↑)o神经纤维失去髓鞘,轴突进入小体内分支盘绕在扁平细胞上。
环层小体

环层小体HE染色3.3×10(上海二医大)
胰腺图示胰腺内一个环层小体经中轴的纵切面,可见中轴部的圆柱体。小体的一侧与神经纤维相连(↑)。

环层小体HE染色3.3×10(上海铁医)
人皮下组织环层小体体积较大,圆形或卵圆形。外周部是由数十层同心圆排列的扁平细胞组成的被囊,神经纤维失去髓鞘,轴突穿入小体中轴的均质状圆柱体内。图示两个环层小体( lamellar corpuscle,Pacinian corpuscle),一个为横切,一个近似纵切(↑)。可见较细的神经纤维束(△)。环层小体感受压觉和振动觉刺激。
肌梭和腱梭

猫肋间肌整装片氯化金染色3.3×10(上海医大)
肌梭( muscle spindle)呈长梭形,内含几条细小的骨骼肌纤维(梭内肌纤维)(intrafusal muscle fiber),外包结缔组织被囊。图示染成黑色的几条神经纤维轴突穿入肌梭内分支缠绕在肌纤维上(↑)。

猫足肌腱整装片氯化金染色3.3×10(上海医大)
图示几支神经纤维轴突进入腱梭内,分支缠绕在几条肌腱纤维上,形成多个腱梭(tendon spindle)。肌梭和腱梭是一种本体感受器,接受肌纤维舒缩时的刺激,经神经反射调节肌纤维的张力和收缩运动。
③运动终板

运动终板猫肋间肌整装片氯化金染色3.3 xl0(上海医大)
运动终板( motor end plate)是一种躯体运动神经末梢,分布于骨骼肌纤维,将神经冲动传递给肌纤维,引起肌纤维的收缩。图示几条神经纤维的轴突(着黑色),其分支末梢呈爪状附在骨骼肌纤维上(↑)。一条有髓运动神经纤维的轴突,可分支支配多条骨骼肌纤维。一个运动神经元(脊髓前角和脑干内)的轴突及其所支配的全部骨骼肌纤维,合称一个运动单位( motor unit)。

